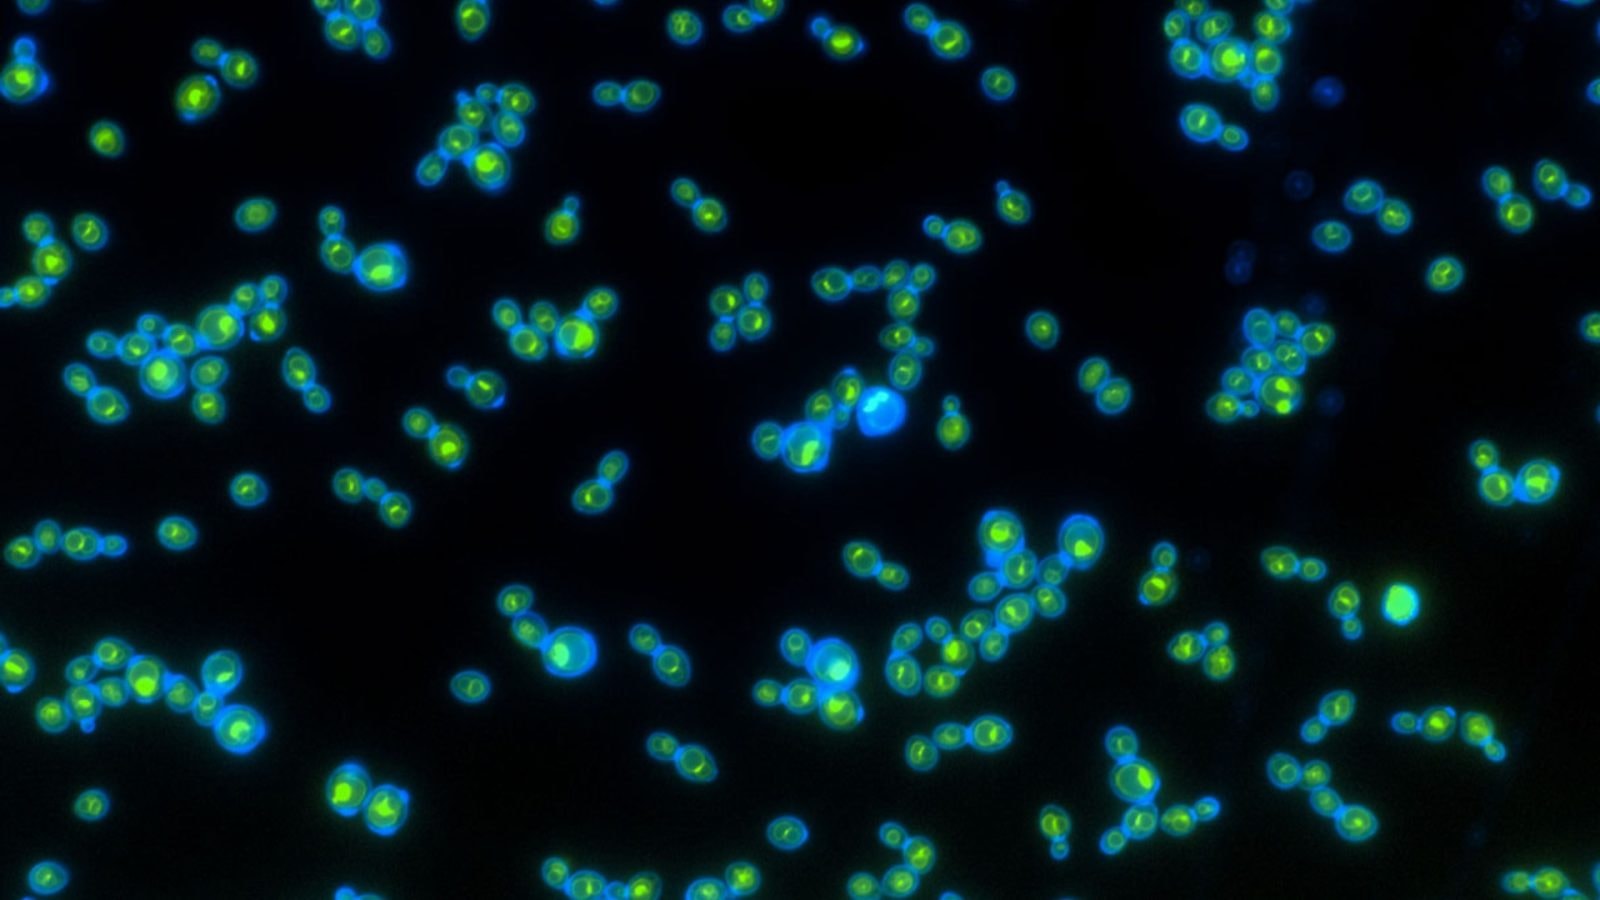
Pierwsze takie organizmy na świecie. Pozyskują energię w niewyobrażalny sposób

Dlaczego mowa o pierwszych takich organizmach na całym świecie? Z prostego powodu: drożdże zwyczajowo nie przepadają – delikatnie mówiąc – za światłem słonecznym. Z tego względu, jeśli mowa o drożdżach spożywczych, producenci zalecają trzymanie ich w zaciemnionych i chłodnych miejscach.
Czytaj też: To największy powerbank świata. Nie stworzył go człowiek
Chcąc to zmienić, przedstawiciele Georgia Tech postanowili opracować organizmy, którym światło słoneczne nie tylko byłoby niestraszne, ale wręcz przeciwnie: służyłoby im do wytwarzania energii. Uzyskany w toku badań szczep ma tak imponujące właściwości, że jego twórcy mówią o fototrofach, czyli organizmach mogących produkować energię ze światła słonecznego.
Kluczem do sukcesu okazał się gen warunkujący szybszy wzrost drożdży w świetle słonecznym niż w ciemności. Różnica nie była duża, bo wynosiła około 2 procent, ale biorąc pod uwagę dotychczasowe zależności, postęp okazał się ogromny. Kulisy badań na ten temat są dostępne w Current Biology. Jak przekonują autorzy publikacji, ich dokonania powinny zapewnić szereg zastosowań.
Zwykle stosowane drożdże piekarskie “nie lubią” światła słonecznego. Te zmodyfikowane przez naukowców z Georgia Tech rozwijają się natomiast szybciej w jego obecności
I nie chodzi wyłącznie o szersze możliwości z zakresu przechowywania drożdży. W grę wchodzi także ich stosowanie do wytwarzania energii, co byłoby prawdziwie rewolucyjnym podejściem. Jak w ogóle członkom zespołu udało się sprawić, by te jednokomórkowe organizmy wytwarzały energię z wykorzystaniem światła słonecznego?
Czytaj też: Polacy zbudują dziwne ekrany akustyczne przy drogach. Surowce wezmą ze starych elektrowni
Uwagę badacze zwróciły rodopsyny, czyli białka odpowiedzialne za tę konwersję. Później pobrali gen rodopsyny pochodzący od pasożytniczego grzyba i wprowadzili go do powszechnie stosowanych drożdży piekarskich. Ostatecznie takie organizmy zaczęły wykazywać niespotykaną do tej pory zależność: rozwijały się w obecności światła słonecznego i to o 2 procent szybciej niż miało to miejsce w ciemności.